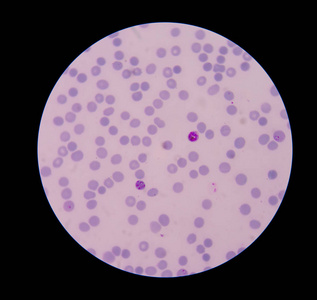
血液红细胞图片

红细胞血影

血涂片为什么我的红细胞是这样的?
图片尺寸2736x3648
尿沉渣涂片未染色(普通光镜)400 × 影红细胞 2018303 箭头所指 "
图片尺寸395x303
尿中异常红细胞请大家讨论
图片尺寸718x536
红色的血液细胞
图片尺寸700x714
见于哪些疾病 ()a,遗传性椭圆性红细胞增多症b,缺铁性贫血c,恶性贫血
图片尺寸253x258
小小血涂片,发现大问题_红细胞
图片尺寸558x432
红细胞|胎儿|胆红素_网易订阅
图片尺寸660x735
小细胞低色素性轻度贫血,直接审核掉?
图片尺寸552x738
图所示红细胞是()
图片尺寸202x177
原始红细胞 18
图片尺寸1080x810
分享一组红细胞被自由基伤害的图片
图片尺寸1036x1381
卫健委临检中心2020年血细胞形态学检查室间质量评价及答案|红细胞
图片尺寸660x481
靶型红细胞
图片尺寸1080x810
由血常规异常参数发现的一例地中海贫血|红细胞|一方_网易订阅
图片尺寸435x434
血液红细胞图片
图片尺寸317x300
所有分类 it/计算机 电脑基础知识 3血液-肌肉1-高护一,红细胞:形态
图片尺寸1080x810
超声的红细胞自显影现象
图片尺寸670x451
血细胞可分为红细胞,白细胞和血小板.
图片尺寸5760x3162
实验诊断学 晚幼红细胞
图片尺寸1080x810
猫瘟|白细胞红细胞骤降|求救
图片尺寸1080x1441